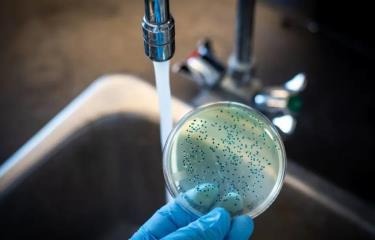

El Ministerio de Salud Pública a través del Viceministerio de Salud Colectiva y su Dirección General de Epidemiologia, notifica a la población, la confirmación mediante análisis correspondientes de cuatro nuevos casos de Cólera, que corresponden a los masculinos de 50, 30, 23 y 4 años de edad respectivamente, todos de nacionalidad dominicana y residentes en el sector la Zurza del Distrito Nacional.
Los pacientes fueron ingresados el pasado jueves 15 del presente mes, luego de presentar diarrea acuosa y blanquecina acompañado de vómitos y boca seca. En el centro de salud fueron hidratados y estabilizados, procediéndose de inmediato a tomar las muestras coprológicas, obteniéndose el resultado positivo a cólera en el día de hoy sábado 17.
El reporte certifica que actualmente los cuatro pacientes llevan más 24 horas sin evacuaciones, manteniéndose todos estables, de buen ánimo y buen apetito, permaneciendo ingresados para fines de observación, con posible de alta en las próximas horas.
De igual manera, la Dirección de Área de Salud IV, conjuntamente con el Viceministerio de Salud Colectiva, su Dirección de Epidemiologia y su Dirección de Gestión de Riesgos, mantienen el cerco epidemiológico, con los familiares cercanos, además de una intervención permanente en la zona para detectar, prevenir e investigar cualquier caso sospechoso de la enfermedad en la zonas de riesgo en la Zurza.
Al mismo tiempo se reporta qué, como parte del monitoreo continuo que hemos tenido en las zonas vulnerables desde octubre, en el estudio más reciente del pasado viernes de las muestras de aguas tomadas en diferentes puntos del Río La Isabela, se encontró presencia de la bacteria Vibrio cholerae.
Salud Pública, como siempre informando con transparencia y a tiempo, exhorta a la población a no alarmarse, a mantenerse atento a nuestros informes, a seguir las medidas de prevención como lavado de manos frecuente, lavar adecuadamente los alimentos, consumir alimentos bien cocidos, solo consumir agua potable y si presentará algún evento diarreico acudir a su centro de salud más cercado para fines de investigación y tratamiento oportuno.
Dirección de Comunicaciones MSP.
Sábado 17 de diciembre, 2022.